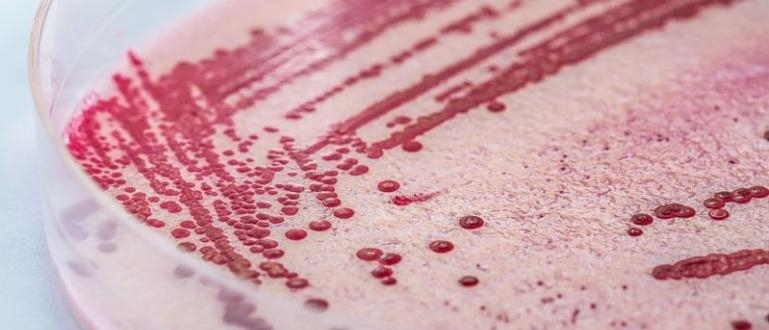
Епидемия от листериоза бактерията в свинското месо е установена

... на 2024 г. Министерството на транспорта също подкрепи инициативата, а служебният министър Красимира Стоянова заяви: "Това е безспорното име, което трябва да носи националното ни летище"
България Порази - Новини
Израелски самолети удариха по обекти на ливанската групировка Хизбула за
...... действия в Сирия. Сирийски бунтовници навлязоха във втория по големина град в страната Алепо за първи път от 8 години насам.Още по темата четете тук:
Украинските сили атакуваха най голямото петролно депо в окупирания Крим Следствие
...... защитата им срещу руските окупатори. Активистът е бил убит по време на боеве в североизточната украинска област Харков. Засега няма други подробности около смъртта му.
Преподавателят в минния факултет на Истанбулския технически университет ИТУ и
...... трябва да се спре, след това застрашените сгради трябва да бъдат обновени изцяло, за да се създадат по-безопасни условия за живот в 16-милионния град." /Марица
Родните ни национали започнаха много силно след като още в
...... на футболист на Англия.С победата България си гарантира място на 1/4-финалите на турнира. Там "лъвовете" ще мерят сили с Азербайджан за място в следващата фаза.
Канцеларията на украинския главен прокурор Андрий Костин уточни че при
...... по-често започна да използва евтините ирански дронове "Шахед", които са трудна мишена за противовъздушната отбрана заради малкия си размер и ниската си скорост, обобщава Ройтерс.
Археолозите са открили край град Бургас рядка икона от ХIV
...... византийски управник. На лицевата ѝ страна са изобразени архангел Гавриил и свети Василий Велики. На обратната страна на иконата от слонова кост откриваме два кръста.
Анализ на германския експерт Кристофер Неринг Дори 30 години след
...... стабилна институция и показахме на обществото кой е имал връзки с ДС. Това разкриване трябва да продължи, трябва да се промени манталитетът на политическия елит!"
ФАКТИ публикува мнения с широк спектър от гледни точки за
...... и показахме на обществото кой е имал връзки с ДС. Това разкриване трябва да продължи, трябва да се промени манталитетът на политическия елит!" Автор Кристофер Неринг
Дори 30 години след падането на комунизма властта на някога вездесъщата Държавна сигурност
...... стабилна институция и показахме на обществото кой е имал връзки с ДС. Това разкриване трябва да продължи, трябва да се промени манталитетът на политическия елит!"
Мрежите от кадри на бившата ДС в България си остават
...... продължи, трябва да се промени манталитетът на политическия елит!"******Вижте и това видео на ДВПроруският вот може да се окаже сериозен фактор на изборите в България
Голямата звезда на балканската музика Лепа Брена е в България
...... много, когато идвам тук, а вие знаете, че серотонинът и всички останали хормони на щастието дават енергия на човек и го подмладяват.“, казва още певицата.
Отборът на България стартира с тежка загуба от Швейцария световните
...... Родригез блокира удара му. Така България ще трябва да се реваншира и да търси достойно представяне срещу Италия след три дни отново на "Васил Левски".
Епидемия от листериоза бактерията в свинското месо е установена
...... дойдохме направо в болницата", каза Алехандро Херера. Здравното министерството там заяви, че проверява още 523 заподозрени случая. Годишно Испания се посещава от 80 млн. туристи.
Епидемия от листериоза бактерията в свинското месо е установена
...... и дойдохме направо в болницата", каза Алехандро Херера.Здравното министерството там заяви, че проверява още 523 заподозрени случая. Годишно Испания се посещава от 80 млн. туристи.
Много силна градушка удари няколко населени места в Северна България
...... ще бъдат процесите в централната част на Дунавската равнина. Там на много места ще има валежи, гръмотевични бури и градушки. След полунощ явленията ще затихват.
Прогнозата на синоптиците за бури и градушки в днешния празничен
...... природната стихия продължила близо половин час. В селото има и изпопадали клони и изпочупени стъкла и керемеди. А повечето местни хора нямат застраховка, предаде БНТ.
София Археолозите са открили край българския град Бургас рядка икона
...... са изобразени архангел Гавриил и свети Василий Велики. На обратната страна на иконата от слонова кост са изобразени два кръста. Превод и редакция: Виктор Турмаков